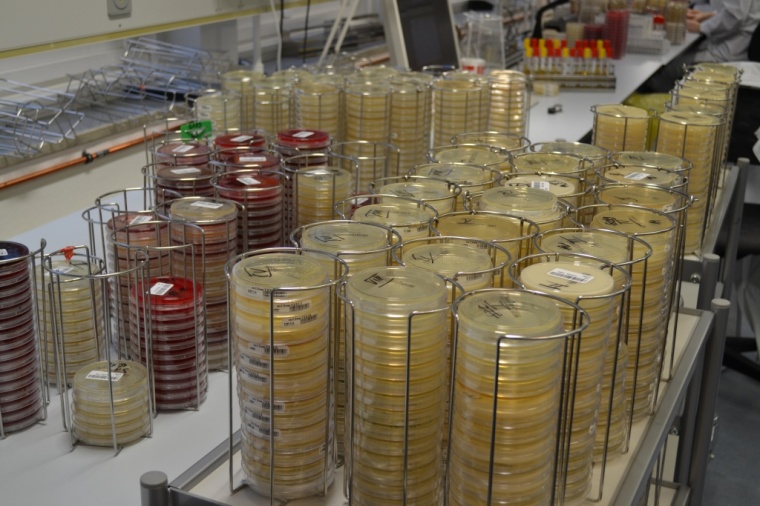
Wachstum von Erregern auf mikrobiologischen Platten im Asklepios-Großlabor...

Hamburger Asklepios Kliniken: Screeningmaßnahmen gegen multiresistente Erreger
Die Hamburger Asklepios Kliniken sind Vorreiter beim Thema Hygiene. Das belegt einmal mehr der aktuelle Hygienebericht der Hamburgischen Krankenhausgesellschaft (HKG). Danach sind die Asklepios Kliniken besonders aktiv, wenn es darum geht, mithilfe von Screeningmaßnahmen die Gefahren einzudämmen, die von den gefährlichen, multiresistenten Bakterien im Krankenhaus ausgehen.
Weil nach aktuellen Erkenntnissen bis zu 90 Prozent der gefährlichen Erreger von den Patienten schon bei der Aufnahme mit in die Klinik gebracht werden, werden bei Asklepios alle Risikopatienten systematisch darauf untersucht, um sie gegebenenfalls rechtzeitig zu isolieren und andere Patienten zu schützen. Das systematische Screening gilt in den sieben großen Hamburger Asklepios Kliniken dabei nicht nur für die bekannten MRSA-Erreger, sondern seit Anfang 2013 auch für die multiresistenten MRGN-Erreger, die sich schnell verbreiten können. Nur wenige andere Kliniken in Hamburg untersuchten ihre Patienten laut Hygienebericht 2014 darauf.
„Asklepios nimmt seit vielen Jahren eine Vorreiterrolle beim Screening auf multiresistente Erreger ein und ist zugleich führend, wenn es darum geht, ihre Verbreitung durch intensive Hygienemaßnahmen einzudämmen. Das alles kommt der Patientensicherheit in unseren Kliniken zugute“, erläutert Dr. Thomas Wolfram, Sprecher der Geschäftsführung der Asklepios Kliniken Hamburg GmbH. Bereits vor mehr als 13 Jahren haben die heutigen Asklepios Kliniken in Hamburg das bundesweit erste klinikübergreifende epidemiologische Netzwerk MRSA ins Leben gerufen. „Wir haben seither jeden einzelnen MRSA-Fall erfasst und analysiert. Wir stellen die Erreger schon bei der Aufnahme des Patienten fest und können deshalb rechtzeitig Schutzmaßnahmen für andere Patienten, für Mitarbeiter und Besucher ergreifen. 2013 haben wir dann zusätzlich zum konsequenten Hygienemanagement und dem Screening auf MRSA auch das Screening auf MRGN, also die resistenten gramnegativen Bakterien eingeführt – lange bevor der Bundesgesundheitsminister eine Regelung im Frühjahr 2015 angemahnt hat. Auch hier nimmt Asklepios in Hamburg zum Schutz der Patienten eine Vorreiterfunktion ein“, so Dr. Wolfram.
Mehr als 140.000 Screeninguntersuchungen in 2015
Allein im Jahr 2014 haben die Hamburger Asklepios Kliniken mit Hilfe ihres Großlabors Medilys im Rahmen der Screeningmaßnahmen über 100.000 Untersuchungen auf multiresistente Erreger wie zum Beispiel MRSA und MRGN durchgeführt. 2015 wurde die Rekordzahl von mehr als 140.000 Screeninguntersuchungen auf diese Erreger veranlasst – ein Zuwachs von fast 50 Prozent. In weniger als fünf Prozent der Fälle gab es ein positives Ergebnis, das zu entsprechenden Schutz- und Isolierungsmaßnahmen führte.
Mehr als 150 Hygienespezialisten im Einsatz
Insgesamt sind bei Asklepios in Hamburg derzeit mehr als 150 Hygienespezialisten im täglichen Einsatz, darunter 123 Hygienebeauftragte Ärzte, 22 hauptberufliche Hygienefachkräfte und elf Krankenhaushygieniker. Darüber hinaus gibt es in den Asklepios Kliniken in jeder Abteilung mindestens eine hygienebeauftragte Pflegekraft.
Patientensicherheit im Fokus
Nach einer von Asklepios im September 2015 veröffentlichten repräsentativen Umfrage zum Thema Patientensicherheit haben zwei von drei Bundesbürgern Angst vor einer Ansteckung mit multiresistenten Erregern. Damit sieht sich Asklepios in seinen Anstrengungen bestätigt, die bestehenden Hygienestandards in der Patientenversorgung auf höchstem Niveau zu halten und wo immer möglich noch zu erweitern. Denn Infektionen mit multiresistenten Erregern sind potenziell lebensbedrohlich und gehen zudem mit hohen Behandlungskosten einher. Ziel ist es daher, die Verbreitung der gefährlichen, weil gegen Antibiotika unempfindlichen Bakterien zu verhindern, das heißt MRSA (Methicillin-resistenter Staphylokokkus aureus) und die ebenfalls hochresistenten gramnegativen Stäbchenbakterien wie E.coli oder Klebsiella pneumoniae aus der Gruppe der multiresistenten gramnegativen Erreger (MRGN) frühzeitig zu erkennen sowie die Patienten sofort zu isolieren und zu behandeln. Dazu dient ein ganzes Bündel an Präventionsmaßnahmen, von der Beschäftigung von ausreichend qualifiziertem Fachpersonal, dem Screening der Patienten bei der Aufnahme über die Schulung des Klinikpersonals bis zur Aufklärung und Einbeziehung der Patienten, Angehörigen und Besucher.










